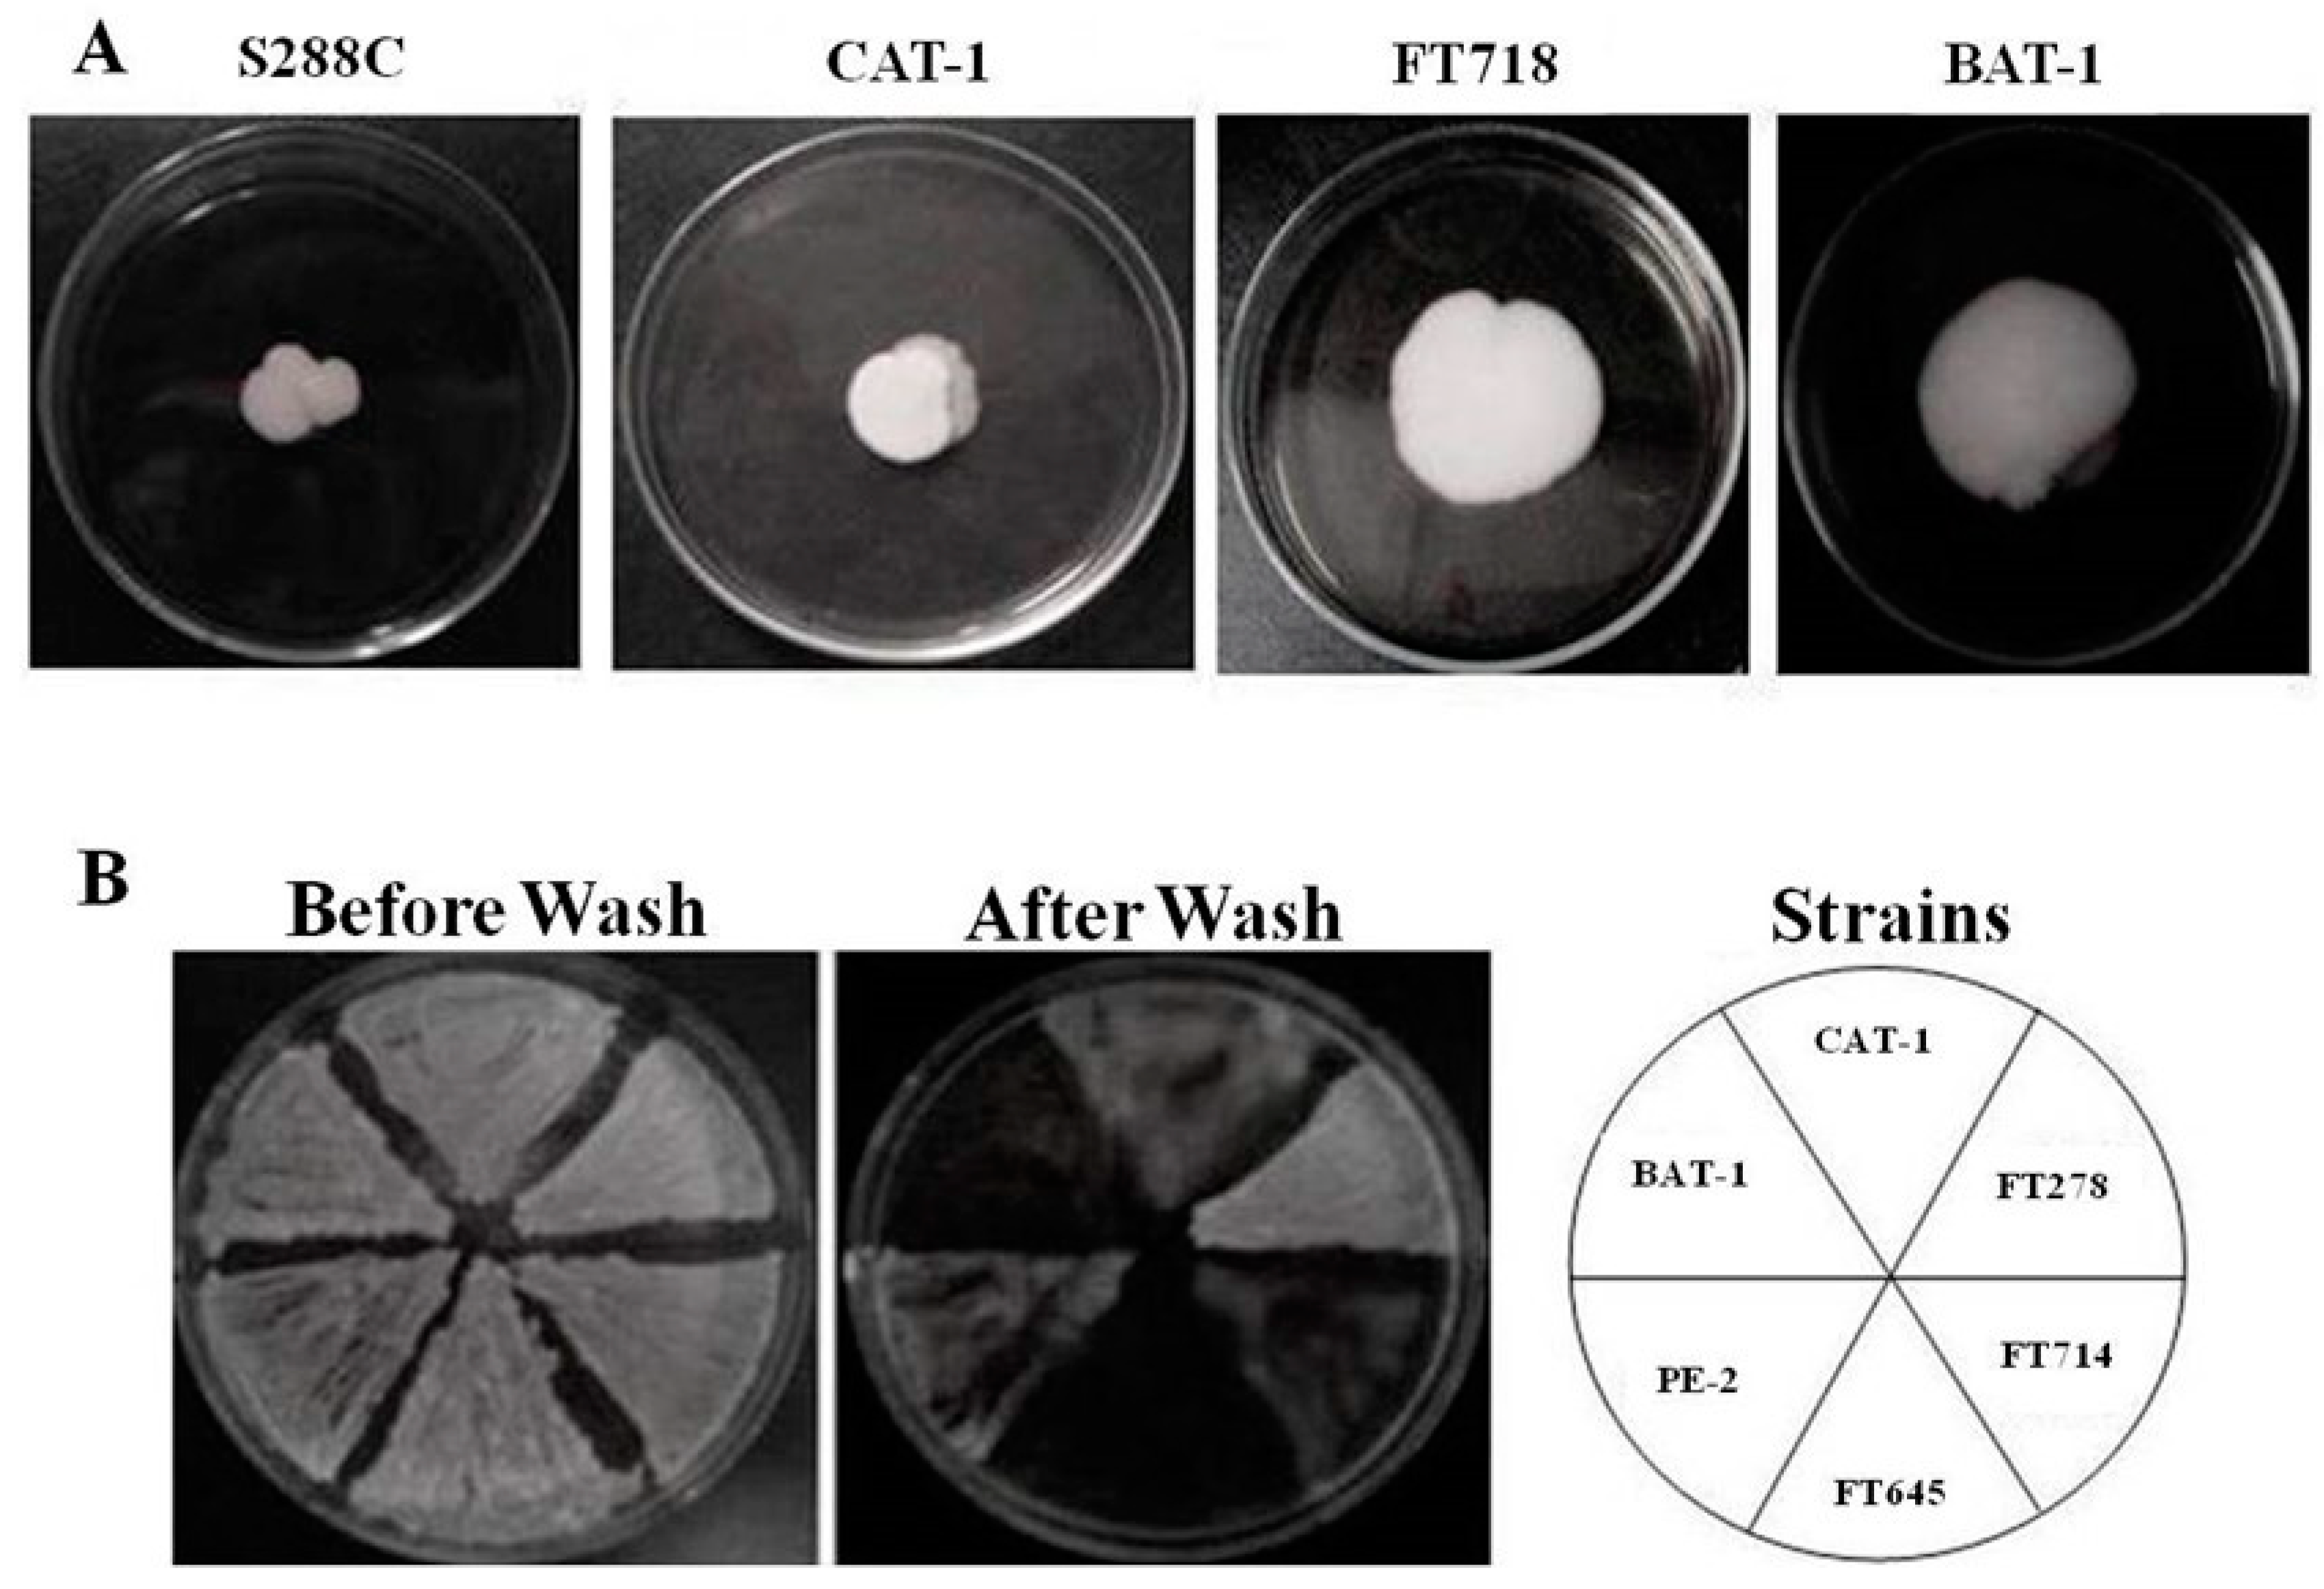
Fermentation 07 00127 g005

High Foam Phenotypic Diversity and Variability in Flocculant Gene Observed for Various Yeast Cell Surfaces Present as Industrial Contaminants
Abstract
1. Introduction
2. Materials and Methods
2.1. Strains, Media, and Growth Conditions
2.2. Foam Quantification
2.3. Flocculation Tests
2.4. Cellular Hydrophobicity Assay
2.5. Biofilm and Invasive Growth Determination
2.6. Amplified Fragment Length Polymorphism Analysis
2.7. Construction of Flo8Δ Knockout Strains
2.8. PFGE, Chromosome Blotting, and Hybridization
3. Results
3.1. Foam Production by Industrial Yeast Strains
3.2. Flocculation and Cellular Hydrophobicity of Industrial Yeast Strains
3.3. Invasive Growth and Biofilm Formation by Industrial Yeast Strains
3.4. Presence and Flocculin Gene Size Polymorphisms
3.5. Deletion of FLO8 Reduces Foam Production by an Industrial Yeast Strain
4. Discussion
5. Conclusions
Author Contributions
Funding
Institutional Review Board Statement
Informed Consent Statement
Data Availability Statement
Conflicts of Interest
References
- Marques, W.L.; Raghavendran, V.; Stambuk, B.U.; Gombert, A.K. Sucrose and Saccharomyces cerevisiae: A relationship most sweet. FEMS Yeast Res. 2016, 16, fov107. [Google Scholar] [CrossRef] [PubMed]
- Jaiswal, D.; de Souza, A.P.; Larsen, S.; LeBauer, D.S.; Miguez, F.E.; Sparovek, G.; Bollero, G.; Buckeridge, M.S.; Long, S.P. Brazilian sugarcane ethanol as an expandable green alternative to crude oil use. Nat. Clim. Change 2017, 7, 788–792. [Google Scholar] [CrossRef]
- Amorim, H.V.; Lopes, M.L.; Oliveira, J.V.C.; Buckeridge, M.S.; Goldman, G.H. Scientific challenges of bioethanol production in Brazil. Appl. Microbiol. Biotechnol. 2011, 91, 1267–1275. [Google Scholar] [CrossRef]
- Della-Bianca, B.E.; Basso, T.O.; Stambuk, B.U.; Basso, L.C.; Gombert, A.K. What do we know about the yeast strains from the Brazilian fuel ethanol industry? Appl. Microbiol. Biotechnol. 2013, 97, 979–991. [Google Scholar] [CrossRef]
- Lopes, M.L.; Paulillo, S.C.; Godoy, A.; Cherubin, R.A.; Lorenzi, M.S.; Giometti, F.H.; Bernardino, C.D.; Amorim Neto, H.B.; Amorim, H.V. Ethanol production in Brazil: A bridge between science and industry. Braz. J. Microbiol. 2016, 47, 64–76. [Google Scholar] [CrossRef]
- Doerfler, J.; Amorim, H.V. Applied bioethanol technology in Brazil. Sugar Ind. 2007, 132, 694–697. [Google Scholar]
- Godoy, A.; Amorim, H.V.; Lopes, M.L.; Oliveira, A.J. Continuous and batch fermentation processes: Advantages and disadvantages of these processes in the Brazilian ethanol production. Int. Sugar J. 2008, 110, 175–181. [Google Scholar]
- Raghavendran, V.; Basso, T.P.; da Silva, J.B.; Basso, L.C.; Gombert, A.K. A simple scaled down system to mimic the industrial production of first generation fuel ethanol in Brazil. Antonie van Leeuwenhoek 2017, 110, 971–983. [Google Scholar] [CrossRef]
- Beckner, M.; Ivey, M.L.; Phister, T.G. Microbial contamination of fuel ethanol fermentations. Lett. Appl. Microbiol. 2011, 53, 387–394. [Google Scholar] [CrossRef] [PubMed]
- Costa, O.Y.A.; Souto, B.M.; Tupinambá, D.D.; Bergmann, J.C.; Kyaw, C.M.; Kruger, R.H.; Barreto, C.C.; Quirino, B.F. Microbial diversity in sugarcane ethanol production in a Brazilian distillery using a culture-independent method. J. Ind. Microbiol. Biotechnol. 2015, 42, 73–84. [Google Scholar] [CrossRef]
- Lucena, B.T.; dos Santos, B.M.; Moreira, J.L.; Moreira, A.P.; Nunes, A.C.; Azevedo, V.; Miyoshi, A.; Thompson, F.L.; de Morais, M.A., Jr. Diversity of lactic acid bacteria of the bioethanol process. BMC Microbiol. 2010, 10, 298. [Google Scholar] [CrossRef]
- Senne de Oliveira Lino, F.; Bajic, D.; Vila, J.C.C.; Sánchez, A.; Sommer, M.O.A. Complex yeast-bacteria interactions affect the yield of industrial ethanol fermentation. Nat. Commun. 2021, 12, 1498. [Google Scholar] [CrossRef] [PubMed]
- de Souza-Liberal, A.T.; Basílio, A.; do Monte Resende, A.; Brasileiro, B.; da Silva-Filho, E.A.; de Morais, J.O.; Simões, D.A.; de Morais, M.A., Jr. Identification of Dekkera bruxellensis as a major contaminant yeast in continuous fuel ethanol fermentation. J. Appl. Microbiol. 2007, 102, 538–547. [Google Scholar] [CrossRef]
- Basílio, A.C.M.; Araújo, P.R.L.; Morais, J.O.F.; Silva-Filho, E.A.; de Morais, M.A., Jr.; Simões, D.A. Detection and identification of wild yeast contaminants of the industrial fuel ethanol fermentation process. Curr. Microbiol. 2008, 56, 322–326. [Google Scholar] [CrossRef]
- De Souza, R.B.; dos Santos, B.M.; de Fátima Rodrigues de Souza, R.; da Silva, P.K.; Lucena, B.T.; de Morais, M.A., Jr. The consequences of Lactobacillus vini and Dekkera bruxellensis as contaminants of the sugarcane-based ethanol fermentation. J. Ind. Microbiol. Biotechnol. 2012, 39, 1645–1650. [Google Scholar] [CrossRef]
- Brexo, R.P.; Sant’Ana, A.S. Impact and significance of microbial contamination during fermentation for bioethanol production. Renew. Sustain. Energy Rev. 2017, 73, 423–434. [Google Scholar] [CrossRef]
- Stambuk, B.U. Yeasts: The Leading Figures on Bioethanol Production. In Ethanol as a Green Alternative Fuel: Insight and Perspectives, 1st ed.; Treichel, H., Alves, S.L., Jr., Fongaro, G., Müller, C., Eds.; Nova Science Publishers Inc.: Hauppauge, NY, USA, 2019; pp. 57–91. [Google Scholar]
- da Silva-Filho, E.; Santos, S.K.; Resende, A.M.; Morais, J.O.; de Morais, M.A., Jr.; Simões, D.A. Yeast population dynamics of industrial fuel-ethanol fermentation process assessed by PCR-fingerprinting. Antonie van Leeuwenhoeck 2005, 88, 13–23. [Google Scholar] [CrossRef] [PubMed]
- Basso, L.C.; de Amorim, H.V.; de Oliveira, A.J.; Lopes, M.L. Yeast selection for fuel ethanol production in Brazil. FEMS Yeast Res. 2008, 8, 1155–1163. [Google Scholar] [CrossRef] [PubMed]
- Tosin, C.; Andrietta, S.R.; Andrietta, M.G.S. Population dynamics of yeasts inhabiting bioethanol production with cell recycling. J. Inst. Brew. 2015, 121, 343–348. [Google Scholar] [CrossRef]
- Reis, V.R.; Antonangelo, A.T.B.F.; Bassi, A.P.G.; Colombi, D.; Ceccato-Antonini, S.R. Bioethanol strains of Saccharomyces cerevisiae characterised by microsatellite and stress resistance. Braz. J. Microbiol. 2017, 48, 268–274. [Google Scholar] [CrossRef] [PubMed]
- da Silva-Filho, E.; Melo, H.F.; Antunes, D.F.; dos Santos, S.K.; Resende, M.A.; Simões, D.A.; de Morais, M.A., Jr. Isolation by genetic and physiological characteristics of a fuel-ethanol fermentative Saccharomyces cerevisiae strain with potential for genetic manipulation. J. Ind. Microbiol. Biotechnol. 2005, 32, 481–486. [Google Scholar] [CrossRef]
- Stambuk, B.U.; Dunn, B.; Alves, S.L., Jr.; Duval, E.H.; Sherlock, G. Industrial fuel ethanol yeasts contain adaptive copy number changes in genes involved in vitamin B1 and B6 biosynthesis. Genome Res. 2009, 19, 2271–2278. [Google Scholar] [CrossRef]
- Ceccato-Antonini, S.R. Biotechnological implications of filamentation in Saccharomyces cerevisiae. Biotechnol. Lett. 2008, 30, 1151–1161. [Google Scholar] [CrossRef]
- Reis, V.R.; Bassi, A.P.G.; Cerri, B.C.; Almeida, A.R.; Carvalho, I.G.B.; Bastos, R.G.; Ceccato-Antonini, S.R. Effects of feedstock and co-culture of Lactobacillus fermentum and wild Saccharomyces cerevisiae strain during fuel ethanol fermentation by the industrial yeast strain PE-2. AMB Express 2018, 8, 23. [Google Scholar] [CrossRef]
- Pelton, R. A review of antifoam mechanisms in fermentation. J. Ind. Microbiol. Biotechnol. 2002, 29, 149–154. [Google Scholar] [CrossRef] [PubMed]
- Junker, B. Foam and its mitigation in fermentation systems. Biotechnol. Prog. 2007, 23, 767–784. [Google Scholar] [CrossRef] [PubMed]
- Nielsen, J.C.; Senne de Oliveira Lino, F.; Rasmussen, T.G.; Thykær, J.; Workman, C.T.; Basso, T.O. Industrial antifoam agents impair ethanol fermentation and induce stress responses in yeast cells. Appl. Microbiol. Biotechnol. 2017, 101, 8237–8248. [Google Scholar] [CrossRef] [PubMed]
- Stewart, G.G. Yeast Flocculation—Sedimentation and Flotation. Fermentation 2018, 4, 28. [Google Scholar] [CrossRef]
- Blasco, L.; Viñas, M.; Villa, T.G. Proteins influencing foam formation in wine and beer: The role of yeast. Int. Microbiol. 2011, 14, 61–71. [Google Scholar] [PubMed]
- Kordialik-Bogacka, E.; Ambroziak, W. Investigation of foam-active polypeptides during beer fermentation. J. Sci. Food. Agric. 2004, 84, 1960–1968. [Google Scholar] [CrossRef]
- Kordialik-Bogacka, E.; Ambroziak, W. The relationship between polypeptides and foaming during fermentation. LWT Food Sci. Technol. 2007, 40, 368–373. [Google Scholar] [CrossRef]
- Chen, Y.; Song, L.; Han, Y.; Liu, M.; Gong, R.; Luo, W.; Guo, X.; Xiao, D. Decreased proteinase A excretion by strengthening its vacuolar sorting and weakening its constitutive secretion in Saccharomyces cerevisiae. J. Ind. Microbiol. Biotechnol. 2017, 44, 149–159. [Google Scholar] [CrossRef] [PubMed]
- Song, L.; Chen, Y.; Guo, Q.; Huang, S.; Guo, X.; Xiao, D. Regulating the Golgi apparatus sorting of proteinase A to decrease its excretion in Saccharomyces cerevisiae. J. Ind. Microbiol. Biotechnol. 2019, 46, 601–612. [Google Scholar] [CrossRef] [PubMed]
- Romano, P.; Suzzi, G.; Vannini, L. Relationship between foaming and flocculence in Saccharomyces cerevisiae wine strains. Colloids Surf. B Biointerfaces 1994, 2, 511–515. [Google Scholar] [CrossRef]
- Palmieri, M.C.; Greenhalf, W.; Laluce, C. Efficient flotation of yeast cells grown in batch culture. Biotechnol. Bioeng. 1996, 50, 248–256. [Google Scholar] [CrossRef]
- Verstrepen, K.J.; Klis, F.M. Flocculation, adhesion and biofilm formation in yeasts. Mol. Microbiol. 2006, 60, 5–15. [Google Scholar] [CrossRef]
- Brückner, S.; Mösh, H.-U. Choosing the right lifestyle: Adhesion and development in Saccharomyces cerevisiae. FEMS Microbiol. Rev. 2012, 36, 25–58. [Google Scholar] [CrossRef]
- van Mulders, S.E.; Christianen, E.; Saerens, S.M.; Daenen, L.; Verbelen, P.J.; Willaert, R.; Verstrepen, K.J.; Delvaux, F.R. Phenotypic diversity of Flo protein family-mediated adhesion in Saccharomyces cerevisiae. FEMS Yeast Res. 2009, 9, 178–190. [Google Scholar] [CrossRef]
- Fichtner, L.L.; Schulze, F.; Braus, G.H. Differential Flo8p-dependent regulation of FLO1 and FLO11 for cell-cell and cell-substrate adherence of S. cerevisiae S288C. Mol. Microbiol. 2007, 26, 1276–1289. [Google Scholar] [CrossRef] [PubMed]
- Dranginis, A.M.; Rauceo, J.M.; Coronado, J.E.; Lipke, P.N. A biochemical guide to yeast adhesins: Glycoproteins for social and antisocial occasions. Microbiol. Mol. Biol. Rev. 2007, 71, 282–294. [Google Scholar] [CrossRef]
- Willaert, R.G. Adhesins of yeasts: Protein structure and interactions. J. Fungi 2018, 4, 119. [Google Scholar] [CrossRef]
- Kraushaar, T.; Brückner, S.; Veelders, M.; Rhinow, D.; Schreiner, F.; Birke, R.; Pagenstecher, A.; Mösch, H.U.; Essen, L.O. Interactions by the fungal Flo11 adhesin depend on a fibronectin type III-like adhesin domain girdled by aromatic bands. Structure 2015, 23, 1005–1017. [Google Scholar] [CrossRef]
- Zara, S.; Bakalinsky, A.T.; Zara, G.; Pirino, G.; Demontis, M.A.; Budroni, M. FLO11-based model for air-liquid interfacial biofilm formation by Saccharomyces cerevisiae. Appl. Environ. Microbiol. 2005, 71, 2934–2939. [Google Scholar] [CrossRef]
- Douglas, L.M.; Li, L.; Yang, Y.; Dranginis, A.M. Expression and characterization of the flocculin FLO11/MUC1, a Saccharomyces cerevisiae mannoprotein with homotypic properties of adhesion. Eukaryot. Cell 2007, 6, 2214–2221. [Google Scholar] [CrossRef] [PubMed]
- Goossens, K.V.Y.; Willaert, R. The N-terminal domain of the FLO11 protein from Saccharomyces cerevisiae is an adhesin without mannose-biding activity. FEMS Yeast Res. 2012, 12, 78–87. [Google Scholar] [CrossRef] [PubMed]
- Goossens, K.V.; Stassen, C.; Stals, I.; Donohue, D.S.; Devreese, B.; De Greve, H.; Willaert, R.G. The N-terminal domain of the Flo1 flocculation protein from Saccharomyces cerevisiae binds specifically to mannose carbohydrates. Eukaryot. Cell 2011, 10, 110–117. [Google Scholar] [CrossRef]
- Veelders, M.; Brückner, S.; Ott, D.; Unverzagt, C.; Mösch, H.U.; Essen, L.O. Structural basis of flocculin-mediated social behavior in yeast. Proc. Natl. Acad. Sci. USA 2010, 107, 22511–22516. [Google Scholar] [CrossRef]
- Smukalla, S.; Caldara, M.; Pochet, N.; Beauvais, A.; Guadagnini, S.; Yan, C.; Vinces, M.D.; Jansen, A.; Prevost, M.C.; Latgé, J.P.; et al. FLO1 is a variable green beard gene that drives biofilm-like cooperation in budding yeast. Cell 2008, 135, 726–737. [Google Scholar] [CrossRef] [PubMed]
- Verstrepen, K.J.; Jansen, A.; Lewitter, F.; Fink, G.R. Intragenic tandem repeats generate functional variability. Nat. Genet. 2005, 37, 986–990. [Google Scholar] [CrossRef] [PubMed]
- Fidalgo, M.; Barrales, R.R.; Jimenez, J. Coding repeat instability in the FLO11 gene of Saccharomyces yeasts. Yeast 2008, 25, 879–889. [Google Scholar] [CrossRef]
- Shimoi, H.; Sakamoto, K.; Okuda, M.; Atthi, R.; Iwashita, K.; Ito, K. The AWA1 gene is required for the foam-forming phenotype and cell surface hydrophobicity of sake yeast. Appl. Environ. Microbiol. 2002, 68, 2018–2025. [Google Scholar] [CrossRef]
- Miyashita, K.; Sakamoto, K.; Kitagaki, H.; Iwashita, K.; Ito, K.; Shimoi, H. Cloning and analysis of the AWA1 gene of a nonfoaming mutant of a sake yeast. J. Biosci. Bioeng. 2004, 97, 14–18. [Google Scholar] [CrossRef]
- Shimizu, M.; Miyashita, K.; Kitagaki, H.; Ito, K.; Shimoi, H. Amplified fragment length polymorphism of the AWA1 gene of sake yeasts for identification of sake yeast strains. J. Biosci. Bioeng. 2005, 100, 678–680. [Google Scholar] [CrossRef] [PubMed]
- Blasco, L.; Veiga-Crespo, P.; Villa, T.G. FPG1, a gene involved in foam formation in Saccharomyces cerevisiae. Yeast 2011, 28, 437–451. [Google Scholar] [CrossRef] [PubMed]
- Blasco, L.; Veiga-Crespo, P.; Sánchez-Pérez, A.; Villa, T.G. Clonning and characterization of the beer foaming gene CFG1 from Saccharomyces pastorianus. J. Agric. Food Chem. 2012, 60, 10796–10807. [Google Scholar] [CrossRef]
- Argueso, J.L.; Carazzolle, M.F.; Mieczkowski, P.A.; Duarte, F.M.; Netto, O.V.; Missawa, S.K.; Galzerani, F.; Costa, G.G.; Vidal, R.O.; Noronha, M.F.; et al. Genome structure of a Saccharomyces cerevisiae strain widely used in bioethanol production. Genome Res. 2009, 19, 2258–2270. [Google Scholar] [CrossRef] [PubMed]
- Babrzadeh, F.; Jalili, R.; Wang, C.; Shokralla, S.; Pierce, S.; Robinson-Mosher, A.; Nyren, P.; Shafer, R.W.; Basso, L.C.; de Amorim, H.V.; et al. Whole-genome sequencing of the efficient industrial fuel-ethanol fermentative Saccharomyces cerevisiae strain CAT-1. Mol. Genet. Genomics 2012, 287, 485–494. [Google Scholar] [CrossRef] [PubMed]
- Wang, D.; Wang, Z.; Liu, N.; He, X.; Zhang, B. Genetic modification of industrial yeast strains to obtain controllable NewFlo flocculation property and lower diacetyl production. Biotechnol. Lett. 2008, 30, 2013–2018. [Google Scholar] [CrossRef] [PubMed]
- Reynolds, T.B.; Fink, G.R. Bakers’ yeast, a model for fungal biofilm formation. Science 2001, 291, 878–881. [Google Scholar] [CrossRef]
- Ausubel, F.M.; Brent, R.; Kingston, R.E.; Moore, D.D.; Seidman, J.G.; Smith, J.A.; Struhl, K. Short Protocols in Molecular Biology, 3rd ed.; John Wiley & Sons: New York, NY, USA, 1995. [Google Scholar]
- Petracek, M.E.; Longtine, M.S. PCR-based engineering of yeast genome. Methods Enzymol. 2002, 350, 445–469. [Google Scholar]
- Gietz, D.; St Jean, A.; Woods, R.A.; Schiestl, R.H. Improved method for high efficiency transformation of intact yeast cells. Nucleic Acids Res. 1992, 20, 1425. [Google Scholar] [CrossRef] [PubMed]
- Guerring, S.L.; Connelly, C.; Hieter, P. Positional mapping of genes by chromosome blotting and chromosome fragmentation. Methods Enzymol. 1991, 194, 57–77. [Google Scholar]
- Stovíček, V.; Váchová, L.; Kuthan, M.; Palková, Z. General factors important for the formation of structured biofilm-like yeast colonies. Fungal Genet. Biol. 2010, 47, 1012–1022. [Google Scholar] [CrossRef]
- Hope, E.A.; Dunham, M.J. Ploidy-regulated variation in biofilm-related phenotypes in natural isolates of Saccharomyces cerevisiae. G3 Gen. Genom. Genet. 2014, 4, 1773–1786. [Google Scholar] [CrossRef]
- Kobayashi, O.; Yoshimoto, H.; Sone, H. Analysis of the genes activated by the FLO8 gene in Saccharomyces cerevisiae. Curr. Genet. 1999, 36, 256–261. [Google Scholar] [CrossRef]
- Kuthan, M.; Devaux, F.; Janderová, B.; Slaninová, I.; Jacq, C.; Palková, Z. Domestication of wild Saccharomyces cerevisiae is accompanied by changes in gene expression and colony morphology. Mol. Microbiol. 2003, 47, 745–754. [Google Scholar] [CrossRef] [PubMed]
- Ryan, O.; Shapiro, R.S.; Kurat, C.F.; Mayhew, D.; Baryshnikova, A.; Chin, B.; Lin, Z.Y.; Cox, M.J.; Vizeacoumar, F.; Cheung, D.; et al. Global gene deletion analysis exploring yeast filamentous growth. Science 2012, 337, 1353–1356. [Google Scholar] [CrossRef]
- van de Velde, S.; Thevelein, J.M. cAMP-PKA and Snf1 signaling mechanisms underlie the superior potency of sucrose for induction of filamentation in yeast. Eukaryot. Cell 2008, 7, 286–293. [Google Scholar] [CrossRef]
- Koschwanez, J.H.; Foster, K.R.; Murray, A.W. Sucrose utilization in budding yeast as a model for the origin of undifferentiated multicellularity. PLoS Biol. 2011, 9, e1001122. [Google Scholar] [CrossRef]
- Koschwanez, J.H.; Foster, K.R.; Murray, A.W. Improved use of a public good selects for the evolution of undifferentiated multicellularity. eLife 2013, 2, e00367. [Google Scholar] [CrossRef]
- Oud, B.; Guadalupe-Medina, V.; Nijkamp, J.F.; de Ridder, D.; Pronk, J.T.; van Maris, A.J.; Daran, J.M. Genome duplication and mutations in ACE2 cause multicellular, fast-sedimenting phenotypes in evolved Saccharomyces cerevisiae. Proc. Natl. Acad. Sci. USA 2013, 110, E4223–E4231. [Google Scholar] [CrossRef]
- Ratcliff, W.C.; Fankhauser, J.D.; Rogers, D.W.; Greig, D.; Travisano, M. Origins of multicellular evolvability in snowflake yeast. Nat. Commun. 2015, 6, 6102. [Google Scholar] [CrossRef] [PubMed]
- Chow, J.; Dionne, H.M.; Prabhakar, A.; Mehrotra, A.; Somboonthum, J.; Gonzalez, B.; Edgerton, M.; Cullen, P.J. Aggregate filamentous growth responses in yeast. mSphere 2019, 4, e00702–e00718. [Google Scholar] [CrossRef]
- Rodrigues-Prause, A.; Sampaio, N.M.V.; Gurol, T.M.; Aguirre, G.M.; Sedam, H.N.C.; Chapman, M.J.; Malc, E.P.; Ajith, V.P.; Chakraborty, P.; Tizei, P.A.; et al. A case study of genomic instability in an industrial strain of Saccharomyces cerevisiae. G3 Gen. Genom. Genet. 2018, 8, 3703–3713. [Google Scholar] [CrossRef] [PubMed]
- Hope, E.A.; Amorosi, C.J.; Miller, A.W.; Dang, K.; Heil, C.S.; Dunham, M.J. Experimental evolution reveals favored adaptive routes to cell aggregation in yeast. Genetics 2017, 206, 1153–1167. [Google Scholar] [CrossRef]
- Liu, H.; Styles, C.A.; Fink, G.R. Saccharomyces cerevisiae S288C has a mutation in FLO8, a gene required for filamentous growth. Genetics 1996, 144, 967–978. [Google Scholar] [CrossRef]
- Fidalgo, M.; Barrales, R.R.; Ibeas, J.I.; Jimenez, J. Adaptive evolution by mutations in the FLO11 gene. Proc. Natl. Acad. Sci. USA 2006, 103, 11228–11233. [Google Scholar] [CrossRef]
- Zara, G.; Zara, S.; Pinna, C.; Marceddu, S.; Budroni, M. FLO11 gene length and transcriptional level affect biofilm-forming ability of wild flor strains of Saccharomyces cerevisiae. Microbiology 2009, 155, 3838–3846. [Google Scholar] [CrossRef]
- Halme, A.; Bumgarner, S.; Styles, C.; Fink, G.R. Genetic and epigenetic regulation of the FLO gene family generates cell-surface variation in yeast. Cell 2004, 44, 405–415. [Google Scholar] [CrossRef]
- Voordeckers, K.; De Maeyer, D.; van der Zande, E.; Vinces, M.D.; Meert, W.; Cloots, L.; Ryan, O.; Marchal, K.; Verstrepen, K.J. Identification of a complex genetic network underlying Saccharomyces cerevisiae colony morphology. Mol. Microbiol. 2012, 86, 225–239. [Google Scholar] [CrossRef] [PubMed]
- Holmes, D.L.; Lancaster, A.K.; Lindquist, S.; Halfmann, R. Heritable remodeling of yeast multicellularity by an environmentally responsive prion. Cell 2013, 153, 153–165. [Google Scholar] [CrossRef]
- Scherz-Andersen, K.; Bojsen, R.; Sørensen, L.G.R.; Weiss, M.; Nielsen, L.M.; Folkesson, A.; Regenberg, B. Genetic basis for Saccharomyces cerevisiae biofilm in liquid medium. G3 Gen. Genom. Genet. 2014, 4, 1671–1680. [Google Scholar]
- Rupp, S.; Summers, E.; Lo, H.J.; Madhani, H.; Fink, G. MAP kinase and cAMP filamentation signaling pathways converge on the unusually large promoter of the yeast FLO11 gene. EMBO J. 1999, 18, 1257–1269. [Google Scholar] [CrossRef]
- Kuchin, S.; Vyas, V.K.; Carlson, M. Snf1 protein kinase and the repressors Nrg1 and Nrg2 regulate FLO11, haploid invasive growth, and diploid pseudohyphal differentiation. Mol. Cell. Biol. 2002, 22, 3994–4000. [Google Scholar] [CrossRef] [PubMed]
- Kayacan, Y.; Van Mieghem, T.; Delvaux, F.; Delvaux, F.R.; Willaert, R. Adaptive evolution of industrial Brewer’s yeast strains towards a snowflake phenotype. Fermentation 2020, 6, 20. [Google Scholar] [CrossRef]

| Relevant Features or Sequence | |
|---|---|
| Plasmids: | |
| pUG6 | LoxP-KanMX6-LoxP [62] |
| pUG66 | LoxP-BleR-LoxP [62] |
| Primers: | |
| AWA1F | CCGAAGCACTTGCAAAGGATGG |
| AWA1R | GGGAGTTGGAAGCAGTTGCGC |
| FLO1F | GGCAGTCTTTACACTTCTGGCAC |
| FLO1R | AGTATTGGTAGTCGTTTCAGCAGC |
| FLO11F | GATGTGACTTCCGTTTCTTGGG |
| FLO11R | CCGTAGTGACTGATGGAGTTGGAG |
| HbFLOsF | CAGAAACAACAAAACAACCA |
| HbFLOsR | TTAAATTAATTGCCAGCAATAAG |
| HbFLO11F | CCGTCGTTACTACTGAGTATTC |
| HbFLO11R | TAGAATACAACTGGAAGAGCG |
| INFLO8F | GTTATAAAGTGAATAGTTCGTATC |
| INFLO8R | CGATCTCAATTTACTGGATAC |
| LIM1FLO8F | CACGGCACGTTACTAATTAG |
| LIM1FLO8R | CAGATTAAGGTTTATGATATTTG |
| LIM2FLO8F | GTGACCATTTTTTACTCCTG |
| LIM2FLO8R | CAAGCTACTTCAATGAGTGTAC |
| M1FLO8F1 | GCCCTGGGAGTGGGATACTGAGGAATTAAACGTTTATGCAGGCCCAGCTGAAGCTTCGTACGC |
| M1FLO8R1 | CCAATCATTCCGGCACATCCACCTTGATCAAATATCATAAACCGCATAGGCCACTAGTGGATC |
| M2FLO8F1 | CGCATTCCGTGGTAGAATGAGTTATAAAGTGAATAGTTCGCCAGCTGAAGCTTCGTACGC |
| M2FLO8R1 | CGTAACTCCATTCTCCTAGCTTTTTATTATGTTTCCTGTCGCATAGGCCACTAGTGGATC |
| SDKANF | CCGCGATTAAATTCCAACAT |
| SDKANR | CGAGCATCAAATGAAACTG |
| SDBLEF | GAGATCTGTTTAGCTTGCCT |
| SDBLER | GTTAGTATCGAATCGACAGCA |
| V1FLO8F | GGCTCTAGTAGTAACAAAAATAG |
| V3FLO8F | CTGAGGGACCTATTGTATGC |
| VKanRR | GGAATCGAATGCAACCGG |
| VBLERF | CCTTCTATGAAAGGTTGGGC |
| Industrial Yeast Strains: | Biofilm (cm) 1 | Invasive Growth 2 | PCR Product 3 (Kb) for Gene: | |
|---|---|---|---|---|
| FLO1 | FLO11 | |||
| CAT-1 | 2.0 | ++ | 1.3 | 2.1 |
| PE-2 | 2.0 | ++ | 0.8 | 0.8 |
| BAT-1 | 4.5 | ─ | 3.2 | 2.7 |
| FT278 | 1.5 | +++ | 2.9 | 2.4 |
| FT279 | 3.0 | ─ | 2.9 | 2.5 |
| FT281 | 1.5 | ─ | 5.0 | 2.8 |
| FT517 | 3.5 | ++ | ─ | 2.6 |
| FT540 | 1.2 | + | 3.2 | 0.5 |
| FT645 | 4.0 | ─ | 3.4 | 2.9 |
| FT697 | 1.5 | ++ | 4.9 | ─ |
| FT699 | 4.0 | ─ | ─ | 2.7 |
| FT705 | 4.0 | + | ─ | 2.7 |
| FT714 | 3.0 | + | ─ | 2.6 |
| FT718 | 4.5 | + | ─ | 2.0 |
| FT859 | 1.6 | ++ | 3.0 | 2.6 |
Publisher’s Note: MDPI stays neutral with regard to jurisdictional claims in published maps and institutional affiliations. |
© 2021 by the authors. Licensee MDPI, Basel, Switzerland. This article is an open access article distributed under the terms and conditions of the Creative Commons Attribution (CC BY) license (https://creativecommons.org/licenses/by/4.0/).
Share and Cite
de Figueiredo, C.M.; Hock, D.H.; Trichez, D.; Magalhães, M.d.L.B.; Lopes, M.L.; de Amorim, H.V.; Stambuk, B.U. High Foam Phenotypic Diversity and Variability in Flocculant Gene Observed for Various Yeast Cell Surfaces Present as Industrial Contaminants. Fermentation 2021, 7, 127. https://doi.org/10.3390/fermentation7030127
de Figueiredo CM, Hock DH, Trichez D, Magalhães MdLB, Lopes ML, de Amorim HV, Stambuk BU. High Foam Phenotypic Diversity and Variability in Flocculant Gene Observed for Various Yeast Cell Surfaces Present as Industrial Contaminants. Fermentation. 2021; 7(3):127. https://doi.org/10.3390/fermentation7030127
Chicago/Turabian Stylede Figueiredo, Catarina M., Daniella H. Hock, Débora Trichez, Maria de Lourdes B. Magalhães, Mario L. Lopes, Henrique V. de Amorim, and Boris U. Stambuk. 2021. "High Foam Phenotypic Diversity and Variability in Flocculant Gene Observed for Various Yeast Cell Surfaces Present as Industrial Contaminants" Fermentation 7, no. 3: 127. https://doi.org/10.3390/fermentation7030127
APA Stylede Figueiredo, C. M., Hock, D. H., Trichez, D., Magalhães, M. d. L. B., Lopes, M. L., de Amorim, H. V., & Stambuk, B. U. (2021). High Foam Phenotypic Diversity and Variability in Flocculant Gene Observed for Various Yeast Cell Surfaces Present as Industrial Contaminants. Fermentation, 7(3), 127. https://doi.org/10.3390/fermentation7030127

